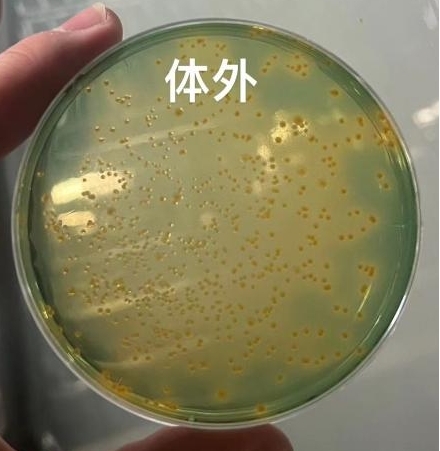
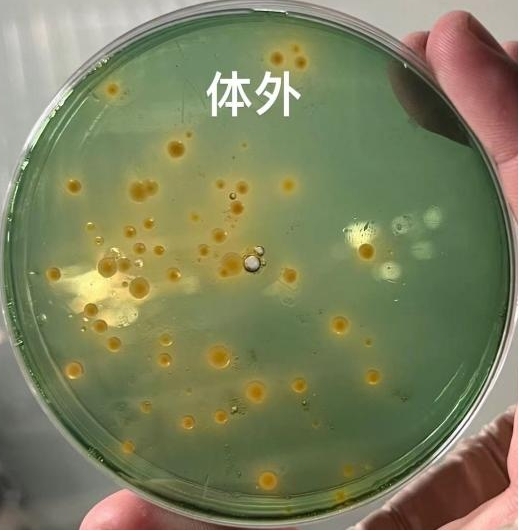

一、什么是弧菌?
1、弧菌并不是特指某一种细菌,弧菌属中已经明确12种具有致病性,包括副溶血弧菌、溶藻弧菌、哈维式弧菌、霍乱弧菌、创伤弧菌、河流弧菌等。
2、弧菌是海洋环境中常见的细菌类群之一,有很强的抗逆性和适应性,是海水环境的优势种群,常作为致病性引起疾病的爆发,是对虾养殖最常见,危害最大的细菌性病害。
3、在自然条件下弧菌是一种条件致病菌,当环境恶化,对虾抵抗力降低时,弧菌就会趁虚而入,大数据表明,对虾的偷死、肠炎、生长缓慢、白便等疾病都与弧菌存在极大的关系。
二、如何防控弧菌?
对虾弧菌的控制,一般有3种方法:
1、控制水环境的弧菌。对虾的消化道与水体相同,水体的微生物组成直接影响对虾消化道的菌相组成。所以水环境中弧菌数量少,就可以预防消化道弧菌感染。这就是水体泼药的主要意义。
控制肠道的弧菌侵袭。常用的有定值能力的乳酸菌,在肠道形成优势种群,粘附在肠道表皮形成生物屏障,使弧菌粘不到肠壁上,避免感染。同时,乳酸菌分泌的乳酸,减低弧菌的毒理、毒力。

大家都知道内服抗菌素和中草药。对抗弧菌效果还是很明显的。但是拌料很关键,有很多养殖户却似白忙活,因为拌料方法不当,撒料过程中,饲料表面的成分在下沉重被洗的干干净净;对虾弧菌病的预防也是看疾病的轻重缓急,采取相应的方法处理。

正确的拌料方法:将可以溶解的成分溶解到水中,可以渗透到饲料里,不易流失。不溶于水的粉剂一般要用粘合剂,而且拌料后要晾干30分钟以上,待表面干燥。
2024年3月
地区:河北省黄骅市
品种:南美白对虾
大小:27m³
对虾吃料变慢,个别池子较严重,肝脏发红,空肠空胃。
弧菌检测:绿弧菌,黄弧菌超标
处理方案:中仁弧立净一瓶三个池子

使用效果:弧菌量明显减少,吃料量可见明显见多。
作用原理:
中仁弧立净主要成分为蛭弧菌,是一类专门以捕食细菌为生的寄生性细菌,它比通常的细菌小,具有细菌的特性,其宿主范围广泛,对大部分阴性菌都有裂解作用,敏感性较高,广谱性的特异性免疫。弧立净繁殖一代需4~6h,每次可复制6~36个子代细胞。弧立净可以在死菌上生长。弧立净的作用可吸附到宿主细胞上并进入宿主细胞内,在其中生长繁殖,最终导致宿主菌源裂解。

本文供稿:孙德康,刘信义
编辑审核:张传宝,臧学运